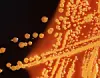
Der er tale om genmodificeret coli-bakterie. Foto: Scanpix

Styrelse advarer: Bakterieudslip i dansk by
Esbjerg Kommune har været ramt af et udslip af genmodificerede bakterier.
Mandag den 25. november er der sket et udslip af genetisk modificerede bakterier til en gårdsplads i Esbjerg Kommune.
Det skriver Miljøstyrelsen i en pressemeddelelse.
Artiklen fortsætter under videoen
Der er tale om bakterien Escherichi coli K12. Altså en coli-bakterie.
Både kommunen, spildevandsanlæg og relevante afdelinger i Miljøstyrelsen er orienteret.
Omfang svært at bedømme
Miljøstyrelsen har i forbindelse med udslippet indhentet faglig bistand hos Nationalt Center for Miljø og Energi.
Det vurderes, at det er svært at bedømme omfanget af udslippet. Samtidig vurderes det dog, at bakterierne får svært ved at kunne etablere sig i det omgivne miljø, og at udslippet derfor “ingen betydelige konsekvenser vil have for mennesker eller det omgivne miljø.”
Ryddet op
Miljøstyrelsen skirver, at jord, der har været udsat for udslippet og flydende affald, er inaktiveret. Grus, der kan indeholde genetisk modificerede organismer, er opsamlet så vidt muligt. Yderligere væske er spulet til gulvafløb uden om regnvandssystemet.
De bakterier, der ikke er spulet væk eller inaktiveret, vil gå i dvale grundet de koldere temperaturer, og vil ikke overleve efterfølgende, grundet manglende næring.
Miljøstyrelsen vil, sammen med virksomheden, gennemgå årsagen til uheldet, for at sikre lignende tilfælde ikke forekommer. I forlængelse heraf aftales der prøvetagning og analyser til påvisning af, at området ikke indeholder levende genetisk modificerede organismer.
Utroligt uheldigt
Udslippet er sket hos virksomheden Glycom, der holder til i Esbjerg-forstaden Kjersing.
Her fortæller fabrikschef Kjeld Kjeldsen, at udslippet skyldtes en mekanisk fejl:
– Det skyldes et mekanisk problem, der har givet et udslip fra nogle rør. Det er så endt uden for det område, hvor vi må opbevare væsken, siger han til Newsbreak.dk.
Han understreger, at der er taget hånd om udslippet, og at det ikke nåede at udvikle sig:
– Vi opdager det heldigvis hurtigt, da vi har en masse overvågning på fabrikken, og får hurtigt taget hånd om det, siger han til Newsbreak.dk.












